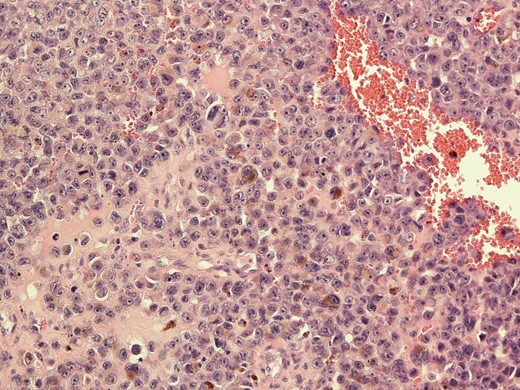
Histological image of metastatic melanoma with intracytoplasmic melanin pigment.

-
PDF
- Split View
-
Views
-
Cite
Cite
Anjana Kaur, Sukh Rayatt, Jagjeevan Jagadeesan, Rahul Hejmadi, Shivram Singh, Metastatic melanoma vs lymphoma. Using a sentinel lymph node biopsy a diagnostic tool, Journal of Surgical Case Reports, Volume 2019, Issue 4, April 2019, rjz117, https://doi.org/10.1093/jscr/rjz117
- Share Icon Share
Abstract
Sentinel lymph node biopsy (SLNB) is a prognostic tool used in cases of melanoma with a stage IB or greater and the absence of clinical lymphadenopathy. A positive SLNB historically indicated a need for regional lymph node clearance. However, cases of clinical lymphadenopathy in the presence of primary melanoma negates the use of SLNB and rather the British Association of Dermatologists advocate a primary block dissection of regional lymphatic tissue [NICE UK. Melanoma: assessment and management. NICE Guideline NG 14. 2015]. The following describes the case of a patient with an original stage II melanoma and a concurrent diagnosis of B cell lymphoma associated with widespread lymphadenopathy. Our multi-disciplinary team believe the use of SLNB is a more informative investigation compared with ultrasonograpphy and fine needle aspiration for such cases. In cases of clinical uncertainty due to a dual diagnosis of lymphoma, cytology would not provide nodal morphology or histological architecture, required for lymphoma grade and subtype.
INTRODUCTION
Sentinel lymph node biopsy (SLNB) and ultrasound/fine needle aspiration cytology SLNB has a high sensitivity and specificity for diagnosing subclinical regional lymph node involvement in metastaic melanoma [1]. Ultrasound and fine needle aspiration cytology (FNAC) is a recognized alternative method for pre-operatively identifying metastatic spread, however, this modality has reduced sensitivity compared with SLNB [2, 3].
The sentinel node is the first lymph node draining a primary tumor site. A SLNB is a minimally invasive procedure performed with the use of blue dye and radiolabelled colloids. The radiolabelled dye identifies the first lymph nodes in the regional basin which receives lymph from the primary melanoma site. As the sentinel node is the initial site of regional metastasis, this process predicts the tumor status of other nodes in the lymphatic basin. If the sentinel node does not identify evidence of metastases, this indicates other regional lymphatic tissue will not harbor metastatic spread of the primary melanoma [4].
UK melanoma management guidelines therefore recommend offering SLNB as a staging procedure for patients with stage IB–IIC melanoma with a breslow thickness of more than 1 mm [5].
SLNB gives valuable prognostic information and identifies patients who would benefit from adjuvant treatment or clinical trial. However, there remains no proven survival benefit or demonstrated therapeutic advantage following SLNB. A false negative rate of 3% is widely accepted and therefore NICE guidelines advocate interpreting SLNB results in context with clinical findings [5].
An association between cutaneous melanoma and non-Hodgkins lymphoma is well documented [2]. The incidence of a diagnosis of cutaneous melanoma in patients with an existing diagnosis of a non-Hodgkin lymphoma such as B cell lymphoma was found to be 0.0007% in a large pooled analysis of published data including 137 162 patients with a primary non-Hodgkin lymphoma [6, 7]. A small yet statistically significant number of patients with melanoma develop lymphoma and vice versa. A 14-year national cohort study in Australia noted 0.3% of over 18 000 melanoma patients had a dual diagnosis of lymphoma, with 45.5.% of this patient group receiving a concurrent diagnosis of melanoma and lymphoma [11].
CASE REPORT
Our patient is a 49-year-old male of Afro-Caribbean descent with a known diagnosis of B cell lymphoma and acral lentigous melanoma. He presented with a pigmented lesion found to be melanoma on his right plantar lateral sole of foot as well as widespread lymphadenopathy.
An incision biopsy revealed a breslow thickness (BT) of 3.4 mm, clark level 4 and he was referred to a plastic surgery department in a tertiary skin cancer network for a wide local excision. As our patient had clinical lymphadenopathy in the right groin and widespread palpable lymph nodes secondary to his concurrent diagnosis of B cell lymphoma, SLNB was discussed within the skin cancer MDT rather than proceeding directly to lypmph node clearance.
Meanwhile a subsequent narrow margin wide local excision found a BT of 1.1 mm and the surgical defect was reconstructed with double stage integra and split thickness skin graft application. A combination of clinical examination and CT imaging identified widespread lymphadenopathy involving bilateral groins, axillae, cervical and intra-abdominal regions. SLNB confirmed a diagnosis of metastatic melanoma in a 8 mm sentinel node. Figure 1 shows the presence of intracytoplasmic melanin pigment seen on histological analysis
Histological image of metastatic melanoma with intracytoplasmic melanin pigment.
In accordance to national guidelines the patient underwent a complete right inguinal block dissection and histological analysis identified a further four melanoma positive lymph nodes. Affected lymph nodes were also reported to have background features of low grade lymphoma. Figure 2 is a histological image illustrating features of metastatic melanoma and lymphoma coexisting in lymphatic tissue.

Microphotograph from node with metastatic melanoma on right and lymphoma involvement left of the slide.
Specimens were tested for PDL 1 and BRAF mutations and found to be negative. These findings were discussed within the skin cancer MDT and a course of adjuvant radiotherapy treatment was recommended. The patient has since been diagnosed with further cutaneous metastases, indicating disease progression to Stage 4 metastatic melanoma. Unfortunately, our patient experienced a further gradual decline over a 3-month period and received a palliative approach to care in the terminal stages of his illness.
DISCUSSION
SLNB is currently used as prognostic tool in the management of melanoma. Improved survival potential following sentinel node biopsy has been suggested following findings of the multi-center selective lymphadenectomy trials (MSLT study groups), however, these trials have received criticism for length of follow up and management of confounding factors [2, 8].
With reference to the presented case, clinicians may have proceeded with lymph node clearance without preliminary sentinel node investigations. However, as groin lymphatic clearance is an invasive surgery with a number of significant risks of post-operative morbidity, this could be subjecting the patient to unnecessary risks considering the diagnostic uncertainty presented by presence of a known diagnosis of lymphoma [6, 8, 9].
Although lymph node core biopsy or USS FNA and flow cytometry can be diagnostic in cases of high grade lymphoma, this approach is associated with a high rate of inconclusive diagnosis compared with surgical excision. This is supported by European society of medical oncology guidelines [6, 7]. Surgical excision enables differentiation of lymph node pathology based on nodal architecture, identification of melanin deposits and morphology.
Had clinicians assumed the groin lymphadenopathy was a probable feature of lymphoma and opted for a watchful waiting approach, the patients’ melanoma metastases involving five pathological lymph nodes would have remained undetected. In cases of widespread lymphadenopathy with unknown primary malignancy, PET-CT imaging has proved useful [10]. However, this modality would not assist with identifying lymph node morphology and whether regional lymphadenopathy was secondary to lymphoma or melanoma.
The patient’s dual diagnosis may also contribute to the aggressive nature of his melanoma progression. NICE guidelines on melanoma management note the rapid progression of disease in immunosupressed patients as would be the case following the systemic effects of B cell lymphoma [5]. In view of our patient’s dual diagnosis with widespread lymphadenopathy, post-operative management and surveillance of further melanoma metastases would differ from current guidelines and would have relied on interval CT imaging.
CONCLUSION
In cases of cutaneous melanoma and lymphoma with widespread lymphadenopathy, patients should undergo SLNB to investigate the presence of metastatic disease rather than proceeding initially with regional lymphatic clearance. In such situations SLNB can assist with the diagnostic challenge of adequate disease staging.
CONFLICT OF INTEREST STATEMENT
None declared.
REFERENCES
- b-cell lymphomas
- cytology
- drug clearance
- fine needle biopsy
- diagnosis, dual (psychiatry)
- tissue dissection
- lymphoid tissue
- lymphoma
- melanoma
- sentinel lymph node biopsy
- diagnosis
- lymph nodes
- patient prognosis
- metastatic melanoma
- clinical diagnostic instrument
- melanoma, stage ii
- lymphadenopathy
- dermatologists